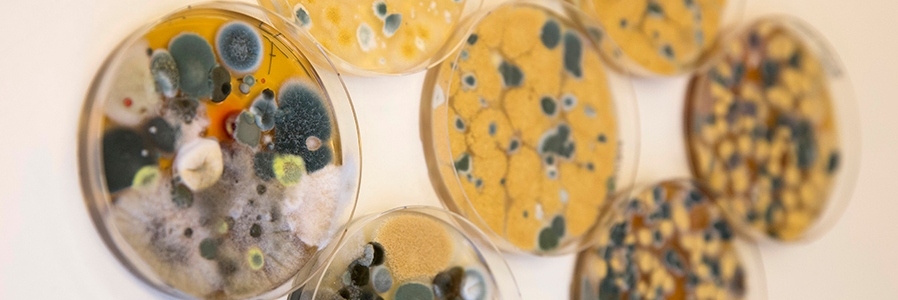
collections

Spring Symposium One Health Mycology
Date:

Spring Symposium One Health Mycology
Venue: Westerdijk Fungal Biodiversity Institute – Auditorium
Uppsalalaan 8, 3584 CT Utrecht, Netherlands
Price: € 200.-
Preliminary program
Monday 13 April 2026
| 08.00-09.00 | Registration |
| 09.00-09.10 | Welcome and Opening Wieland Meyer |
| 09.10-09.50 | Plenary 1: Animal/Human Health Chair: Wieland MeyerSpeaker: Isabella Gremiao (Brazil) Title: “The emergence of Sporotrichosis – the link between Environment, and Animal and Human Infections” |
| 09.50-11.20 | Veterinary Health Chair: Patrizia Danesi (Italy) (1 x 20 min and 4 x15 min Talks)
|
| 11.20-11.40 | Coffee Break |
| 11.40-13.10 | Human Health Chair: Ferry Hagen (Netherlands) (1 x 20 min and 4 x15 min talks)
|
| 13.10-14.00 | Lunch Break |
| 14.00-14.40 | Plenary 2: Soil Health Chair: Camille Delavaux (Netherlands)Liesje Mommer (Netherlands) Title: “Living Soils Under Pressure: Learning from Nature to Restore Ecosystem Services and Build Food System Resilience” |
| 14.40-16.00 | Soil Health Chair: Camille Delavaux (Netherlands) (1 x 20 min and 4 x15 min talks)
|
| 16.00-16.20 | Coffee Break |
| 16.20-17.00 | Plenary 3: Plant Health Chair: Pedro Crous (Netherlands)Bernard Slippers (South Africa) Title: “Silent Threats: How latent pathogens reshape forest health in a changing climate” |
| 17.00-18.15 | Plant Health Chair: Ewald Groenewald (Netherlands) (5 x15 min talks)
|
| 18.15-20.00 | Reception Hubrecht/Westerdijk – Cafeteria |
Tuesday 14 April 2026
| 09.00-09.40 | Plenary 3: Human Health Chair: Sybren de Hoog (Netherlands)Aristea Velegraki/Michael Arabatzis (Greece) Title: “The changing landscape of fungal diseases and antifungal resistance through the lens of climate variability and change.” |
| 09.40-11.00 | Drivers and development of antifungal resistance Chair: Paul Verweij (Netherlands) (1 x 20 min and 4 x15 min talks)
|
| 11.00-11.30 | Coffee Break |
| 11.30-13.00 | Fungal solutions for One Health Chair: Jérôme Collemare (Netherlands) (1 x 20 min and 4 x15 min talks)
|
| 13.00-14.00 | Lunch |
| 14.00-14.30 | Westerdijk Awards Wieland Meyer (Netherlands) |
| 14.30-16.30 | Fungi in Indoor and Food Environments: Health and Food Safety Perspectives – Celebrating the 80th Birthday of Rob Samson Chair: Jos Houbraken (Netherland) (1 x 20 min, 5 x 15 min talks)
|
| 16.30-17.00 | Closing Wieland Meyer (Netherlands) |